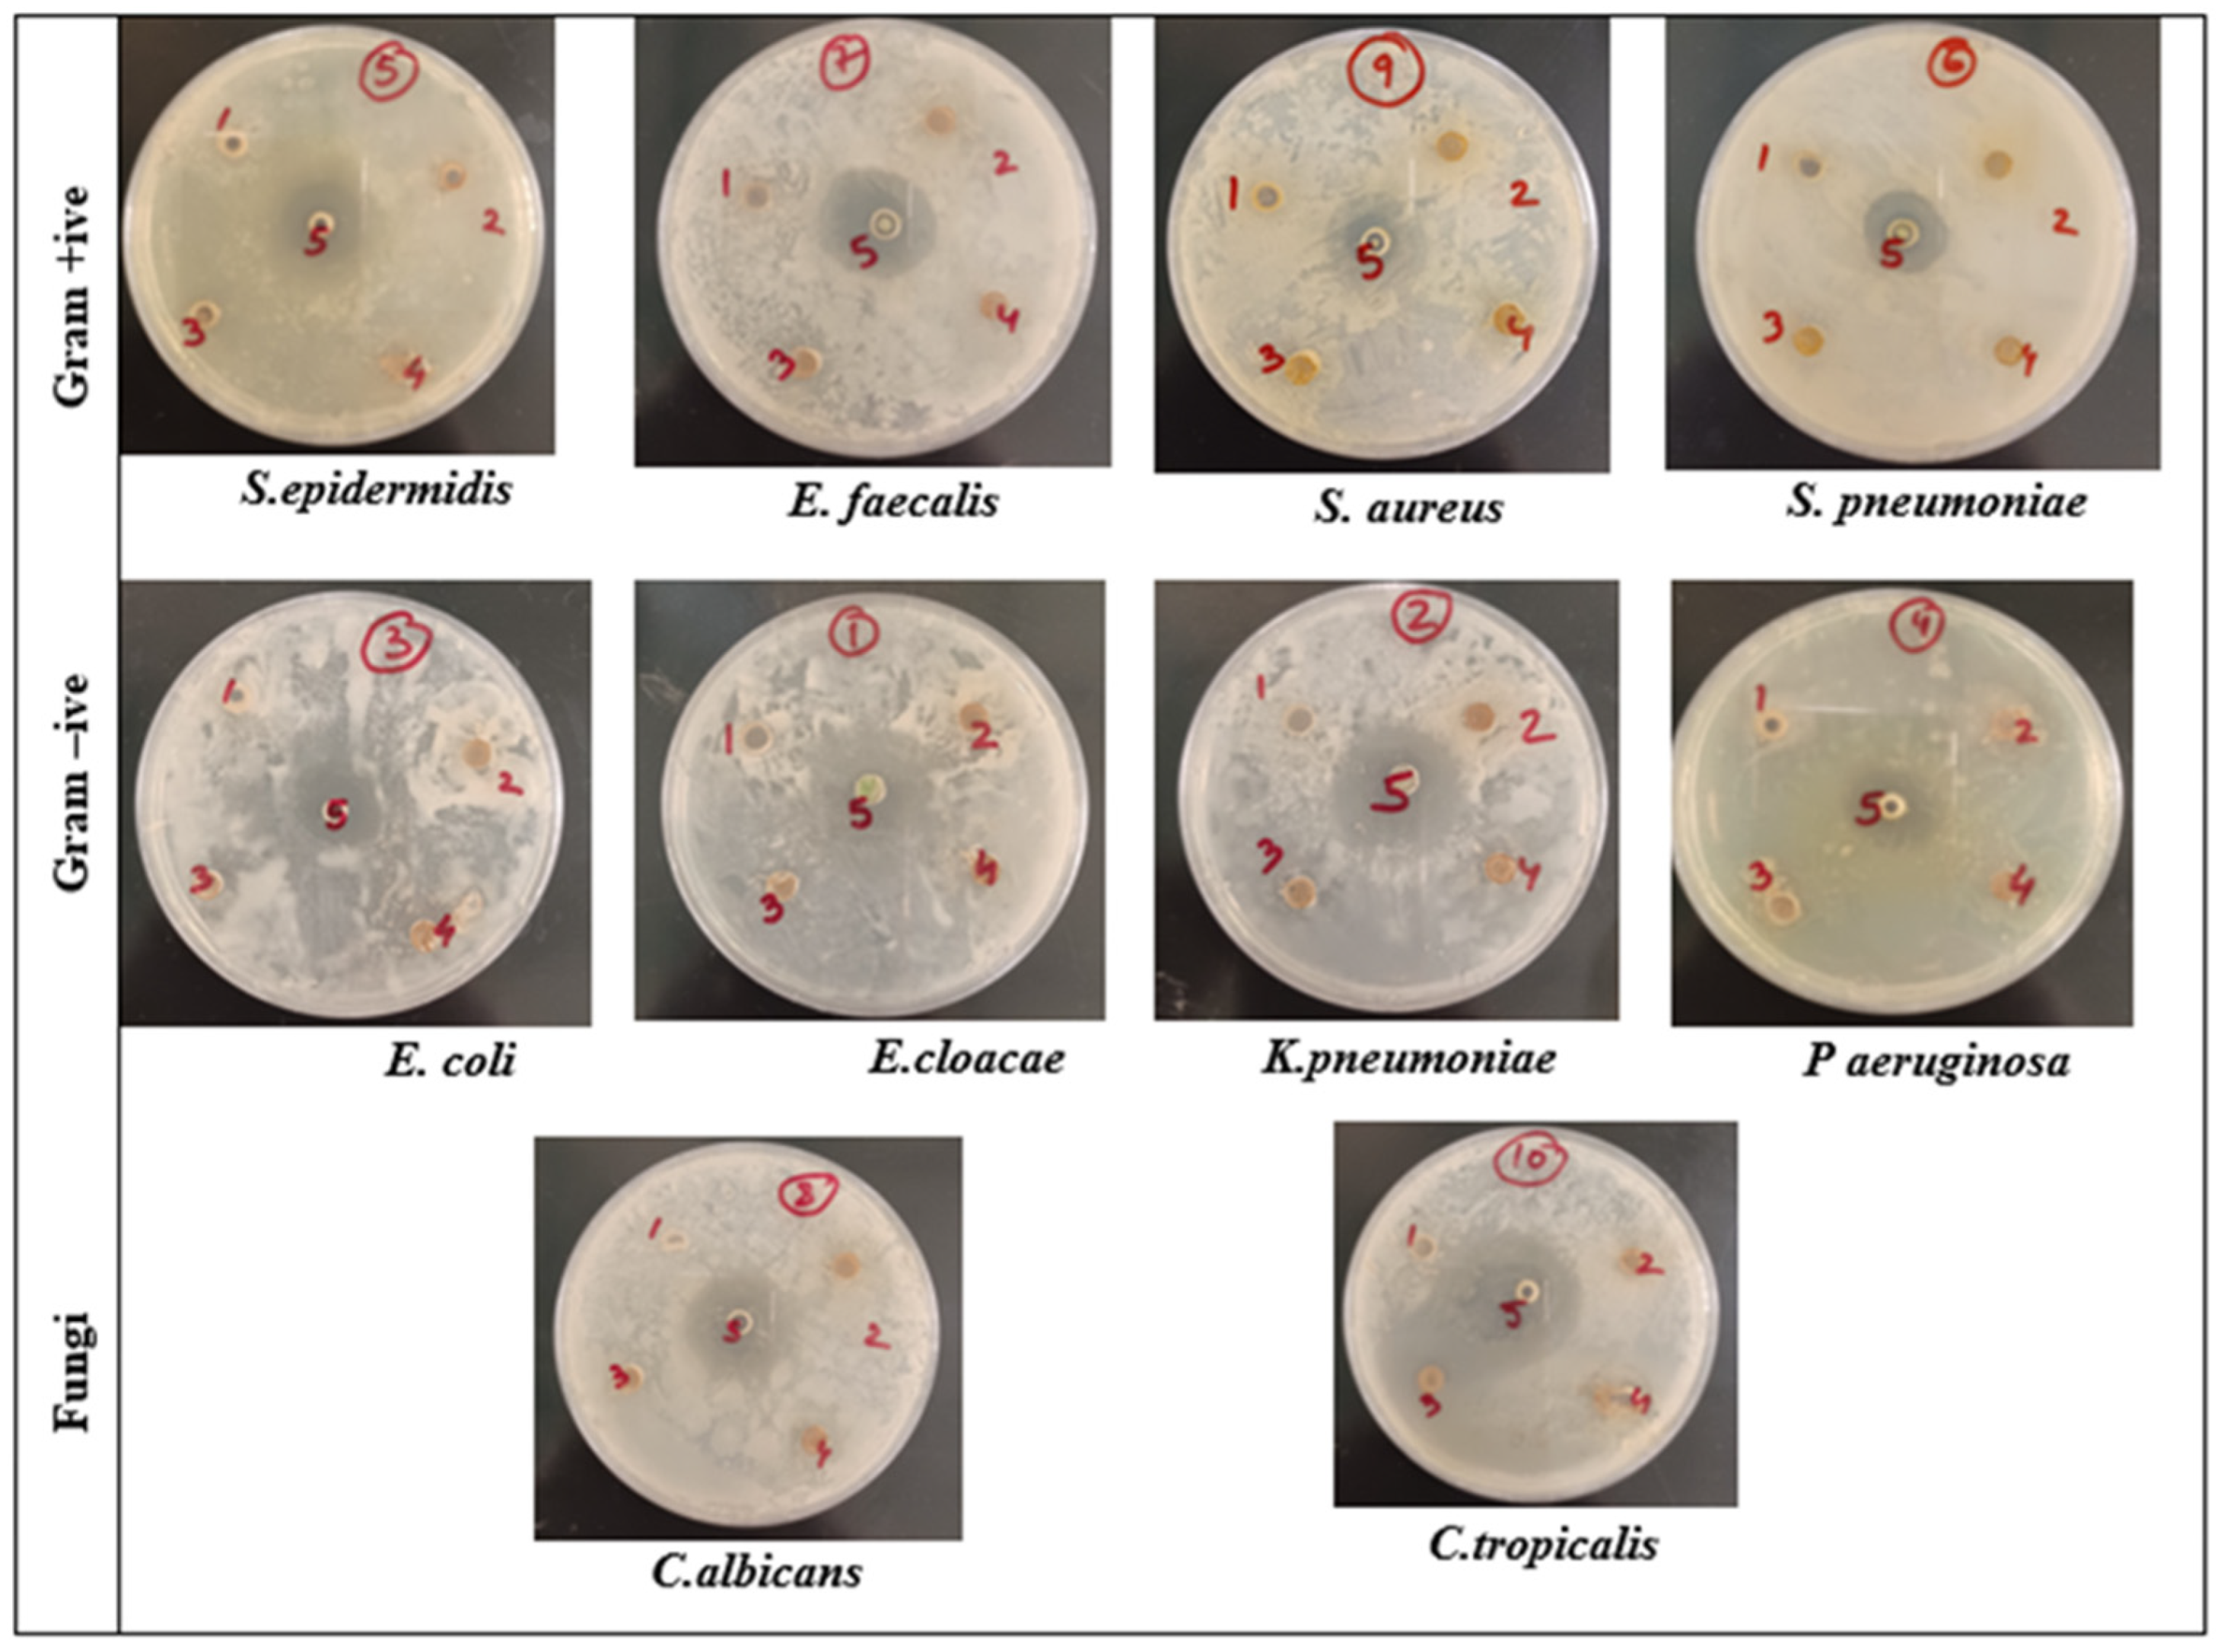
Microbiolres 14 00128 g006 Microbiolres 14 00128 g006

Green Synthesis of Nickel Nanoparticles Using Salvadora persica and Their Application in Antimicrobial Activity against Oral Microbes
Abstract
1. Introduction
2. Materials and Methods
2.1. The Chemical Reagents
2.2. Preparation of the S. persica Extract
2.3. Green Synthesis of Nickel Oxide Nanoparticles Using S. persica (SP-NiONPs)
2.4. Characterization of the SP-NiONPs
2.5. Antioxidant Activity
2.5.1. DPPH Radical Scavenging Assay
2.5.2. ABTS•+ Radical Cation Scavenging Assay
2.6. Antibacterial Assay
2.6.1. Media Preparation
2.6.2. Microbial Strains
2.6.3. Agar Well Diffusion Assay
2.6.4. Determination of the Minimum Inhibitory (MIC) and Minimum Bactericidal Concentrations (MBC)
2.6.5. Scanning Electronic Microscope (SEM) Examination
3. Results and Discussion
3.1. Characterization of the SP-NiONPs
3.2. Antioxidant Activity
3.3. Antimicrobial Activity
4. Conclusions
Author Contributions
Funding
Institutional Review Board Statement
Informed Consent Statement
Data Availability Statement
Conflicts of Interest
References
- Xu, X.; He, J.; Xue, J.; Wang, Y.; Li, K.; Zhang, K.; Guo, Q.; Liu, X.; Zhou, Y.; Cheng, L.; et al. Oral cavity contains distinct niches with dynamic microbial communities. Environ. Microbiol. 2015, 17, 699–710. [Google Scholar] [CrossRef] [PubMed]
- Van’t Hof, W.; Veerman, E.C.; Nieuw Amerongen, A.V.; Ligtenberg, A.J. Antimicrobial defense systems in saliva. Monogr. Oral. Sci. 2014, 24, 40–51. [Google Scholar] [PubMed]
- Marsh, P.D.; Devine, D.A. How is the development of dental biofilms influenced by the host? J. Clin. Periodontol. 2011, 38 (Suppl. S11), 28–35. [Google Scholar] [CrossRef] [PubMed]
- Dewhirst, F.E.; Chen, T.; Izard, J.; Paster, B.J.; Tanner, A.C.; Yu, W.H.; Lakshmanan, A.; Wade, W.G. The human oral microbiome. J. Bacteriol. 2010, 192, 5002–5017. [Google Scholar] [CrossRef]
- Yazdanian, M.; Rostamzadeh, P.; Rahbar, M.; Alam, M.; Abbasi, K.; Tahmasebi, E.; Tebyaniyan, H.; Ranjbar, R.; Seifalian, A.; Yazdanian, A. The potential application of green-synthesized metal nanoparticles in dentistry: A comprehensive review. Bioinorg. Chem. Appl. 2022, 2022, 2311910. [Google Scholar] [CrossRef]
- Lahiri, D.; Ray, R.R.; Sarkar, T.; Upadhye, V.J.; Ghosh, S.; Pandit, S.; Pati, S.; Edinur, H.A.; Abdul Kari, Z.; Nag, M.; et al. Anti-biofilm efficacy of green-synthesized ZnO nanoparticles on oral biofilm: In vitro and in silico study. Front. Microbiol. 2022, 13, 939390. [Google Scholar] [CrossRef]
- Sen, D.; Patil, V.; Smriti, K.; Varchas, P.; Ratnakar, R.; Naik, N.; Kumar, S.; Saxena, J.; Kapoor, S. Nanotechnology and Nanomaterials in Dentistry: Present and Future Perspectives in Clinical Applications. Eng. Sci. 2022, 20, 14–24. [Google Scholar] [CrossRef]
- Narender, S.S.; Varma, V.V.S.; Srikar, C.S.; Ruchitha, J.; Varma, P.A.; Praveen, B.V.S. Nickel oxide nanoparticles: A brief review of their synthesis, characterization, and applications. Chem. Eng. Technol. 2022, 45, 397–409. [Google Scholar] [CrossRef]
- Suresh, K.C.; Balamurugan, A. Evaluation of structural, optical, and morphological properties of nickel oxide nanoparticles for multi-functional applications. Inorg. Nano-Met. Chem. 2020, 51, 296–301. [Google Scholar] [CrossRef]
- Danjumma, S.G.; Abubakar, Y.; Suleiman, S. Nickel oxide (NiO) devices and applications: A review. Int. J. Eng. Res. Technol. 2019, 8, 12–21. [Google Scholar]
- Berhe, M.G.; Gebreslassie, Y.T. Biomedical Applications of Biosynthesized Nickel Oxide Nanoparticles. Int. J. Nanomed. 2023, 18, 4229–4251. [Google Scholar] [CrossRef] [PubMed]
- Hafeez, M.; Shaheen, R.; Akram, B.; Ahmed, M.N.; Haq, S.; Din, S.U.; Zeb, M.; Khan, M.A. Green synthesis of nickel oxide nanoparticles using Populus ciliata leaves extract and their potential antibacterial applications. South Afr. J. Chem. 2021, 75, 168–173. [Google Scholar] [CrossRef]
- Antunes Filho, S.; Dos Santos, M.S.; Dos Santos, O.A.L.; Backx, B.P.; Soran, M.L.; Opriş, O.; Lung, I.; Stegarescu, A.; Bououdina, M. Biosynthesis of Nanoparticles Using Plant Extracts and Essential Oils. Molecules 2023, 28, 3060. [Google Scholar] [CrossRef]
- Al-Zaqri, N.; Umamakeshvari, K.; Mohana, V.; Muthuvel, A.; Boshaala, A. Green synthesis of nickel oxide nanoparticles and its photocatalytic degradation and antibacterial activity. J. Mater. Sci. Mater. Electron. 2022, 33, 11864–11880. [Google Scholar] [CrossRef]
- Anand, G.T.; Nithiyavathi, R.; Ramesh, R.; Sundaram, S.J.; Kaviyarasu, K. Structural and optical properties of nickel oxide nanoparticles: Investigation of antimicrobial applications. Surf. Interfaces 2020, 18, 100460. [Google Scholar] [CrossRef]
- Rheima, A.; Anber, A.A.; Shakir, A.; Salah, H.A.; Hameed, S. Novel method to synthesis nickel oxide nanoparticles for antibacterial activity. Iran. J. Phys. Res. 2020, 20, 51–55. [Google Scholar]
- Sabouri, Z.; Akbari, A.; Hosseini, H.A.; Hashemzadeh, A.; Darroudi, M. Eco-friendly biosynthesis of nickel oxide nanoparticles mediated by okra plant extract and investigation of their photocatalytic, magnetic, cytotoxicity, and antibacterial properties. J. Clust. Sci. 2019, 30, 1425–1434. [Google Scholar] [CrossRef]
- Akhtar, J.; Siddique, K.M.; Bi, S.; Mujeeb, M. A review on phytochemical and pharmacological investigations of miswak (Salvadora persica Linn). J. Pharm. Bioallied Sci. 2011, 3, 113. [Google Scholar]
- Ohtani, K.; Kasai, R.; Yamasaki, K.; Tanaka, O.; Kamel, M.S.; Assaf, M.H.; El-Shanawani, A.A.; Ali, A.A. Lignan glycosides from stems of Salvadora persica. Phytochemistry 1992, 31, 2469–2471. [Google Scholar] [CrossRef]
- Ahmad, H.; Ahamed, N.; Dar, J.M.; Mohammad, U.J. Ethnobotany, pharmacology and chemistry of Salvadora persica L. A review. Res. Plant Biol. 2012, 2, 2565. [Google Scholar]
- Ibrahim, A.Y.; El-Gengaihi, S.E. Safety profile of meswak root extract on liver, kidney, sexual hormones and hematological parameters of rats. Not. Sci. Biol. 2012, 4, 18–23. [Google Scholar] [CrossRef][Green Version]
- Gupta, A.; Verma, S.; Kushwaha, P.; Srivastava, S.; Rawat, A. Phytochemical and antioxidant studies of Salvadora persica L. stem and twig. Indian Pharm. Educ. Res. 2015, 49, 71–75. [Google Scholar] [CrossRef]
- Iyer, D.; Patil, U.K. Efficacy of stigmast-5-en-3b-ol isolated from Salvadora persica L. as antihyperlipidemic and anti-tumor agent: Evidence from animal studies. Asian Pac. J. Trop. Dis. 2012, 2 (Suppl. S2), S849–S855. [Google Scholar] [CrossRef]
- Iyer, D.; Patil, U. Evaluation of antihyperlipidemic and antitumor activities of isolated coumarins from Salvadora indica. Pharm. Biol. 2014, 52, 78–85. [Google Scholar] [CrossRef]
- Lica, I.C.L.; dos Santos Soares, A.M.; de Mesquita, L.S.S.; Malik, S. Biological Properties and pharmacological potential of plant exudates. Food Res. Int. 2018, 105, 1039–1053. [Google Scholar] [CrossRef]
- Uddin, S.; Safdar, L.B.; Iqbal, J.; Yaseen, T.; Laila, S.; Anwar, S.; Abbasi, B.A.; Saif, M.S.; Quraishi, U.M. Green synthesis of nickel oxide nanoparticles using leaf extract of Berberis balochistanica: Characterization, and diverse biological applications. Microsc. Res. Technol. 2021, 84, 2004–2016. [Google Scholar] [CrossRef]
- Wang, Y.; Gao, Y.; Ding, H.; Liu, S.; Han, X.; Gui, J.; Liu, D. Subcritical ethanol extraction of flavonoids from Moringa oleifera leaf and evaluation of antioxidant activity. Food Chem. 2017, 218, 152–158. [Google Scholar] [CrossRef]
- Mohan, R.; Birari, R.; Karmase, A.; Jagtap, S.; Bhutani, K.K. Antioxidant activity of a new phenolic glycoside from Lagenaria siceraria Stand. fruits. Food Chem. 2012, 132, 244–251. [Google Scholar] [CrossRef]
- Al-Dbass, A.M.; Daihan, S.A.; Al-Nasser, A.A.; Al-Suhaibani, L.S.; Almusallam, J.; Alnwisser, B.I.; Saloum, S.; Alotaibi, R.S.; Alessa, L.A.; Bhat, R.S. Biogenic Silver Nanoparticles from Two Varieties of Agaricus bisporus and Their Antibacterial Activity. Molecules 2022, 27, 7656. [Google Scholar] [CrossRef]
- Srihasam, S.; Thyagarajan, K.; Korivi, M.; Lebaka, V.R.; Mallem, S.P.R. Phytogenic generation of NiO nanoparticles using Stevia leaf extract and evaluation of their in-vitro antioxidant and antimicrobial properties. Biomolecules 2020, 10, 89. [Google Scholar] [CrossRef]
- Mandal, B.K.; Mandal, R.; Sikdar, S.; Sarma, S.; Srinivasan, A.; Chowdhury, S.R.; Das, B.; Das, R. Green synthesis of NiO nanoparticle using Punica granatum peel extract and its characterization for methyl orange degradation. Mater. Today Commun. 2023, 34, 105302. [Google Scholar] [CrossRef]
- Hong, J.; Kim, C.; In, C.M.; Kim, S.; Cho, W.J.; Pecunia, V.; Lee, M.J.; Hwang, I. Serendipitous Doping in Nickel Oxide upon Microwave-Induced Low-Temperature Crystallization Enhances Efficiency of Perovskite Solar Cells. Solar RRL 2022, 6, 2100992. [Google Scholar] [CrossRef]
- Bhat, R.S.; Alghamdi, J.M.; Aldbass, A.M.; Aljebrin, N.A.; Alangery, A.B.; Soliman, D.A.; Al-Daihan, S. Biochemical and FT-IR profiling of Tritium aestivum L. seedling in response to sodium fluoride treatment. Fluoride 2022, 55, 81–89. [Google Scholar]
- Bhat, R.S.; Aldbass, A.M.; Alghamdi, J.M.; Alonazia, M.A.; Al-Daihana, S. Trigonella foenum-graecum L. seed germination under sodium halide salts exposure. Fluoride 2023, 56, 168–179. [Google Scholar]
- Abdelmigid, H.M.; Hussien, N.A.; Alyamani, A.A.; Morsi, M.M.; AlSufyani, N.M.; Kadi, H.A. Green synthesis of zinc oxide nanoparticles using pomegranate fruit peel and solid coffee grounds vs. chemical method of synthesis, with their biocompatibility and antibacterial properties investigation. Molecules 2022, 27, 1236. [Google Scholar] [CrossRef] [PubMed]
- Sharma, N.K.; Vishwakarma, J.; Rai, S.; Alomar, T.S.; AlMasoud, N.; Bhattarai, A. Green route synthesis and characterization techniques of silver nanoparticles and their biological adeptness. ACS Omega 2022, 7, 27004–27020. [Google Scholar] [CrossRef]
- Khan, N.A.; Saeed, K.; Khan, I.; Gul, T.; Sadiq, M.; Uddin, A.; Zekker, I. Efficient photodegradation of orange II dye by nickel oxide nanoparticles and nanoclay supported nickel oxide nanocomposite. Appl. Water Sci. 2022, 12, 131. [Google Scholar] [CrossRef]
- Dehno Khalaji, A. Nickel Oxide (NiO) nanoparticles prepared by solid-state thermal decomposition of Nickel (II) schiff base precursor. J. Ultrafine Grained Nanostruct. Mater. 2015, 48, 1–4. [Google Scholar]
- Uddin, S.; Safdar, L.B.; Anwar, S.; Iqbal, J.; Laila, S.; Abbasi, B.A.; Saif, M.S.; Ali, M.; Rehman, A.; Basit, A.; et al. Green synthesis of nickel oxide nanoparticles from Berberis balochistanica stem for investigating bioactivities. Molecules 2021, 26, 1548. [Google Scholar] [CrossRef]
- Mervat, E.H.; Ali, H.M.; Ashmawy, N.A.; Salem, M.Z.M. Chemical composition and bioactivity of Salvadora persica extracts against some potato bacterial pathogens. BioResources 2017, 12, 1835–1849. [Google Scholar]
- Hossain, M.L.; Lim, L.Y.; Hammer, K.; Hettiarachchi, D.; Locher, C. A Review of commonly used methodologies for assessing the antibacterial activity of honey and honey products. Antibiotics 2022, 11, 975. [Google Scholar] [CrossRef] [PubMed]
- Khalil, A.T. Benzylamides from Salvadora persica. Arch. Pharmacal Res. 2006, 29, 952–956. [Google Scholar] [CrossRef] [PubMed]
- Sofrata, A.; Santangelo, E.M.; Azeem, M.; Borg-Karlson, A.K.; Gustafsson, A.; Pütsep, K. Benzyl isothiocyanate, a major component from the roots of Salvadora persica is highly active against Gram-negative bacteria. PLoS ONE 2011, 6, e23045. [Google Scholar] [CrossRef]
- Allandale, H.; Almesaileikh, E.; Bhardwaj, R.G.; Al Khabbaz, A.; Karched, M. The Effect of Benzyl Isothiocyanate on the Expression of Genes Encoding NADH Oxidase and Fibronectin-Binding Protein in Oral Streptococcal Biofilms. Front. Oral. Health 2022, 3, 863723. [Google Scholar] [CrossRef] [PubMed]
- Balhaddad, A.A.; Mokeem, L.; Melo, M.A.S.; Gregory, R.L. Antibacterial Activities of Methanol and Aqueous Extracts of Salvadora persica against Streptococcus mutans Biofilms: An In Vitro Study. Dent. J. 2021, 9, 143. [Google Scholar] [CrossRef] [PubMed]
- Shnawa, B.H.; Jalil, P.J.; Hamad, S.M.; Ahmed, M.H. Antioxidant, protoscolicidal, hemocompatibility, and antibacterial activity of nickel oxide nanoparticles synthesized by ziziphus spina-christi. BioNanoSci 2022, 12, 1264–1278. [Google Scholar] [CrossRef]
- Angel Ezhilarasi, A.; Judith Vijaya, J.; Kaviyarasu, K.; John Kennedy, L.; Ramalingam, R.; Al-Lohedan, H.A. Green synthesis of NiO nanoparticles using Aegle marmelos leaf extract for the evaluation of in-vitro cytotoxicity antibacterial photocatalytic properties. J. Photochem. Photobiol. B Biol. 2018, 180, 39–50. [Google Scholar] [CrossRef]
- Prabhu, S.; Thangadurai, T.D.; Bharathy, P.V.; Kalugasalam, P. Synthesis and characterization of nickel oxide nanoparticles using Clitoria ternatea flower extract: Photocatalytic dye degradation under sunlight and antibacterial activity applications. Results Chem. 2022, 4, 100285. [Google Scholar] [CrossRef]
- Rajith Kumar, C.R.; Betageri, V.S.; Nagaraj, G.; Pujar, G.H.; Suma, B.P.; Latha, M.S. Photocatalytic nitrite sensing antibacterial studies of facile bio-synthesized nickel oxide nanoparticles. J. Sci. Adv. Mater. Dev. 2020, 5, 48–55. [Google Scholar] [CrossRef]
- Slavin, Y.N.; Asnis, J.; Häfeli, U.O.; Bach, H. Metal nanoparticles: Understanding the mechanisms behind antibacterial activity. J. Nanobiotechnol. 2017, 15, 65. [Google Scholar] [CrossRef]
- Behera, N.; Arakha, M.; Priyadarshinee, M.; Pattanayak, B.S.; Soren, S.; Jha, S.; Mallick, B.C. Oxidative stress generated at nickel oxide nanoparticle interface results in bacterial membrane damage leading to cell death. RSC Adv. 2019, 9, 24888–24894. [Google Scholar] [CrossRef] [PubMed]
- Jubu, P.R.; Yam, F.K.; Igba, V.M.; Beh, K.P. Tauc-plot scale and extrapolation effect on bandgap estimation from UV–vis–NIR data—A case study of β-Ga2O3. J. Solid-State Chem. 2020, 290, 121576. [Google Scholar] [CrossRef]
- Juan, C.A.; Perez de la Lastra, J.M.; Plou, F.J.; Perez-Lebena, E. The Chemistry of Reactive Oxygen Species (ROS) Revisited: Outlining Their Role in Biological Macromolecules (DNA, Lipids and Proteins) and Induced Pathologies. Int. J. Mol. Sci. 2021, 22, 4642. [Google Scholar] [CrossRef] [PubMed]

| Sample | IC50 DPPH• (μg mL−1) | IC50 ABTS• + (μg mL−1) |
|---|---|---|
| S. persica extract | 59.12 ± 0.37 | 62.25 ± 1.27 |
| NiONPs | 51.45 ± 0.67 | 54.13 ± 0.98 |
| Ascorbic acid | 23.36 | 25.16 ± 0.41 |
| Strains | Zone of Inhibition (mm) | |||
|---|---|---|---|---|
| A.E. | E.E. | NiONPs | ||
| Gram + ve | Staphylococcus epidermidis 12228 | 9 ± 0.50 | 10 ± 0.10 | 20 ± 0.50 |
| Enterococcus faecalis 51299 | 8 ± 0.50 | 9 ± 0.10 | 24 ± 0.50 | |
| Staphylococcus aureus Rosenbach BAA-1026 | 8 ± 0.30 | 9 ± 0.40 | 22 ± 0.10 | |
| Streptococcus pneumoniae 49619 | 7 ± 1.00 | 8 ± 0.50 | 18 ± 0.50 | |
| Gram − ve | Escherichia coli 35218 | 10 ± 0.50 | 11 ± 0.40 | 20 ± 0.20 |
| Enterobacter cloacae 13047 | 8 ± 0.30 | 9 ± 0.20 | 31 ± 0.50 | |
| Klebsiella pneumoniae BAA-1705 | 7 ± 0.10 | 8 ± 0.10 | 27 ± 0.10 | |
| Pseudomonas aeruginosa 27853 | 8 ± 1.00 | 8 ± 0.20 | 18 ± 0.50 | |
| Fungi | Candida albicans 66027 | 9 ± 0.50 | 10 ± 0.40 | 26 ± 0.10 |
| Candida tropicalis 66029 | 8 ± 0.40 | 9 ± 0.50 | 29 ± 0.40 | |
| Strains | NiONPs | ||
|---|---|---|---|
| MIC μg/mL | MBC μg/mL | ||
| Gram + ve | Staphylococcus epidermidis 12228 | 31.25 | 125.00 |
| Enterococcus faecalis 51299 | 15.62 | 62.50 | |
| Staphylococcus aureus Rosenbach BAA-1026 | 31.25 | 125.00 | |
| Streptococcus pneumoniae 49619 | 125.00 | 250.00 | |
| Gram − ve | Escherichia coli 35218 | 125.00 | 250.00 |
| Enterobacter cloacae 13047 | 15.62 | 62.50 | |
| Klebsiella pneumoniae BAA-1705 | 31.25 | 125.00 | |
| Pseudomonas aeruginosa 27853 | 125.00 | 250.00 | |
| Fungi | Candida albicans 66027 | 62.50 | 125.00 |
| Candida tropicalis 66029 | 15.00 | 62.50 | |
Disclaimer/Publisher’s Note: The statements, opinions and data contained in all publications are solely those of the individual author(s) and contributor(s) and not of MDPI and/or the editor(s). MDPI and/or the editor(s) disclaim responsibility for any injury to people or property resulting from any ideas, methods, instructions or products referred to in the content. |
© 2023 by the authors. Licensee MDPI, Basel, Switzerland. This article is an open access article distributed under the terms and conditions of the Creative Commons Attribution (CC BY) license (https://creativecommons.org/licenses/by/4.0/).
Share and Cite
Balto, H.; Amina, M.; Bhat, R.S.; Al-Yousef, H.M.; Auda, S.H.; Elansary, A. Green Synthesis of Nickel Nanoparticles Using Salvadora persica and Their Application in Antimicrobial Activity against Oral Microbes. Microbiol. Res. 2023, 14, 1879-1893. https://doi.org/10.3390/microbiolres14040128
Balto H, Amina M, Bhat RS, Al-Yousef HM, Auda SH, Elansary A. Green Synthesis of Nickel Nanoparticles Using Salvadora persica and Their Application in Antimicrobial Activity against Oral Microbes. Microbiology Research. 2023; 14(4):1879-1893. https://doi.org/10.3390/microbiolres14040128
Chicago/Turabian StyleBalto, Hanan, Musarat Amina, Ramesa Shafi Bhat, Hanan M. Al-Yousef, Sayed H. Auda, and Afaf Elansary. 2023. "Green Synthesis of Nickel Nanoparticles Using Salvadora persica and Their Application in Antimicrobial Activity against Oral Microbes" Microbiology Research 14, no. 4: 1879-1893. https://doi.org/10.3390/microbiolres14040128
APA StyleBalto, H., Amina, M., Bhat, R. S., Al-Yousef, H. M., Auda, S. H., & Elansary, A. (2023). Green Synthesis of Nickel Nanoparticles Using Salvadora persica and Their Application in Antimicrobial Activity against Oral Microbes. Microbiology Research, 14(4), 1879-1893. https://doi.org/10.3390/microbiolres14040128

